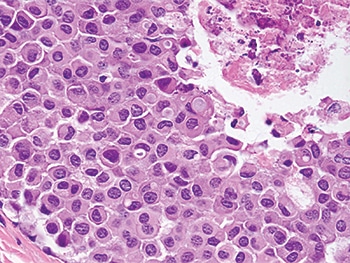
Fig. 5

Karen Lusky
April 2018—DCIS or LCIS? Making the distinction can be difficult in some cases. Stuart J. Schnitt, MD, in a session at CAP17 on ancillary testing in breast pathology, delineated the reasons and provided tips, including the role of E-cadherin immunostains to help in this distinction. The cells of DCIS typically show strong membrane staining for E-cadherin while the cells of LCIS are typically E-cadherin negative. But among the tips: If an in situ lesion is E-cadherin positive, it doesn’t automatically mean it’s ductal carcinoma in situ. As he demonstrated in several cases, the lesion could be lobular carcinoma in situ with aberrant E-cadherin immunostaining.

In the session last fall and in a recent interview, Dr. Schnitt, chief of breast oncologic pathology at Dana-Farber/Brigham and Women’s Cancer Center, explained ways to differentiate LCIS, particularly its variant forms, from DCIS and to detect the aberrant E-cadherin expression seen in LCIS. He and others CAP TODAY interviewed talked about the genomic traits of LCIS variants and the debate about how extensively to treat non-classical LCIS. “One major problem,” he tells cap today, “is there aren’t a lot of data on the subsequent breast cancer risk associated with the variant forms of LCIS.”
Histology is still “the first line of distinction” in differentiating LCIS from DCIS in problematic cases, but in some cases pathologists have to resort to adjunctive immunostains, of which E-cadherin is clearly the “workhorse,” he said. p120 catenin and beta-catenin can be useful in some cases, he illustrated later.

Dr. Schnitt shared a case in which the screening mammogram of a 47-year-old woman exhibited new microcalcifications. He described an image of the core biopsy as clearly showing “an in situ carcinoma composed of a solid proliferation of relatively small cells with low-to-intermediate grade nuclei.” There is “no evidence of lumen formation, no micropapillations, no cribriforming.” (Fig. 1). At somewhat higher power, there’s “a little area of necrosis and a relatively uniform population of cells,” and perhaps some dyshesion (Fig. 2).
A case like this is “really tough to categorize on H&E alone,” Dr. Schnitt said, so the differential diagnosis was DCIS versus LCIS. He showed an image of the E-cadherin staining (Fig. 3). “One way to view this is to say, ‘Wow, it’s positive; therefore it’s DCIS,’ but quite frankly I think it looks a little funny,” he told the audience. “There is clearly membrane staining, but there seems to be a fair amount of cytoplasmic staining as well, which is not typical for DCIS.”

Reserving the final diagnosis for the end of his talk, Dr. Schnitt discussed why pathologists might have trouble telling DCIS and LCIS apart. “There clearly is an overlap in the distribution within the ductal-lobular system; DCIS can involve identifiable lobules and LCIS can involve ducts.”

In addition, some LCIS lesions have features that are more commonly associated in pathologists’ minds with DCIS and vice versa, Dr. Schnitt pointed out. Take, for example, pleomorphic LCIS, which he describes as having considerable variation in cell and nuclear size and shape. It was first reported in 1996 that “you can have this pleomorphic variant of LCIS in association with pleomorphic invasive lobular carcinomas, and then it was found that it can exist as an isolated lesion,” Dr. Schnitt said in an interview. Before 1996, it’s likely these lesions were simply called DCIS.
Dr. Schnitt presented an image of pleomorphic LCIS, predicting that “any reasonable pathologist” viewing something like it at low power would say the lesion looks like it’s probably DCIS (Fig. 4). He pointed to a solid proliferation of very atypical cells in the various spaces with areas of comedo necrosis and calcifications and, at higher power, “marked nuclear pleomorphism” (Fig. 5).
He shared an example of LCIS with necrosis. “And again, I think any reasonable pathologist would first look at this and say, ‘Well, it looks like DCIS’ because it does look like DCIS—solid proliferation, areas of comedo necrosis, and calcifications—but at a higher power the cells look more lobular than ductal,” he said (Figs. 6 and 7).
Intracytoplasmic vacuoles, pagetoid ductal involvement, and loss of cellular cohesion should all make pathologists think of an LCIS variant instead of DCIS, Dr. Schnitt said, presenting a table summarizing the histologic features he views as most useful in distinguishing between LCIS variants and DCIS (Table 1). Dyshesion is a useful clue that the lesion is LCIS rather than DCIS, he says. “One of the characteristic features of LCIS is that the cells don’t stick together very well because they typically lose E-cadherin, which is a cell adhesion molecule,” he says. Although that’s one of the characteristic features of LCIS, including the variant forms, it’s not always observed, Dr. Schnitt adds, noting that he’s seen more cohesive lesions that are LCIS.

“Certainly, in the guilt-by-association category,” if there’s associated classical LCIS, “you should be thinking that perhaps this is more likely a lobular variant than DCIS,” he said. “Conversely, if you see cells polarizing around microacini and polarization of cells at the periphery of the involved spaces, you should start thinking more ductal than lobular carcinoma in situ.” Sometimes it’s impossible on H&E sections alone for pathologists to know for sure if they are dealing with DCIS or LCIS, he added, in which case immunostains are used.
“Loss of E-cadherin expression is arguably the defining feature of LCIS and invasive lobular carcinoma,” Dr. Schnitt said. “E-cadherin molecules are involved in homodimerization on adjacent cells, which holds the cells together.” The intracellular domain of the E-cadherin molecule is connected to the actin cytoskeleton by a variety of catenins, including beta-catenin and p120 catenin, he said. Together, these catenins and E-cadherin make up what has been referred to as the “cadherin-catenin complex.”

Many of the cases showing loss of E-cadherin expression have loss of heterozygosity at the site of the E-cadherin gene at 16q22. “This is often accompanied by inactivating mutations or promoter methylation of CDH1,” he said. Other mechanisms may also result in E-cadherin loss, “but whatever the combination of events, it results in biallelic silencing of the gene and loss of protein expression.”
Dr. Schnitt presented an example of LCIS involving a lobule that he noted has total loss of E-cadherin expression (Fig. 8). The uninvolved lobule on the right side of the left image shows membrane expression in the epithelial cells. In the image on the right, he pointed out “pagetoid involvement in the duct by LCIS. The LCIS cells are negative. The residual epithelial cells are positive.”
“In contrast, DCIS is typically E-cadherin positive with strong membrane staining for E-cadherin,” Dr. Schnitt said. Whether it’s low-grade cribriform or a high-grade comedo, “DCIS is virtually always E-cadherin positive.” (Fig. 9).
In a separate CAP17 presentation on high-risk breast lesions in core biopsies, Sandra J. Shin, MD, professor and chair, Department of Pathology and Laboratory Medicine, Albany Medical College, reported that she uses E-cadherin all of the time. “It’s very helpful when you are trying to decide between LCIS or DCIS,” she said, “especially when you are thinking it may be DCIS extending into adjacent lobules, and there’s loss of E-cadherin expression indicative of LCIS or ALH [atypical lobular hyperplasia].”
Dr. Schnitt said he thinks it’s probably safe to say that loss of E-cadherin expression by immunohistochemistry is characteristic of LCIS, but the converse is not necessarily true. “That is, the presence of E-cadherin expression does not preclude a diagnosis of LCIS in the context of the appropriate histologic features.”

Many pathologists are inclined to look at E-cadherin staining in a binary way, he says. If the lesion is positive, they call it ductal; if it’s negative, the lesion is considered to be lobular. “But we know that you can get aberrant E-cadherin expression in LCIS cells,” he says. “We also know that normal ductal epithelial cells or myoepithelial cells that are admixed with the LCIS cells are E-cadherin positive, and those cells can be misconstrued as the LCIS cells themselves staining for E-cadherin.”
He presented an example of LCIS involving a duct with preexisting usual ductal hyperplasia (UDH) (Fig. 10). “If you do an E-cadherin stain on this, you find that the UDH is positive, the LCIS cells are negative, but if you don’t recognize morphologically that this is UDH, you might say some of the neoplastic cells are E-cadherin positive; therefore, this might be interpreted as DCIS or mixed DCIS and LCIS,” he said.

Studies have shown that about 15 percent of invasive lobular carcinoma display aberrant E-cadherin expression. “The frequency with which you see aberrant E-cadherin expression in LCIS is not as well studied,” Dr. Schnitt said. “Relatively small numbers of cases have been reported in the literature, with aberrant expression ranging from zero in some studies to almost 10 percent in other studies.” His group’s consultation practice sees aberrant E-cadherin expression in LCIS in more than 10 percent of its cases.

The most common pattern of aberrant expression Dr. Schnitt sees is “membranous expression that’s fragmented or partial or beaded and reduced compared to normal epithelial cells.” He has also seen cases in which the staining is “complete and circumferential.”
The intensity of the E-cadherin staining in LCIS, when present, is usually weak or moderate, but it can be strong in some places, and can be either diffuse or focal. “Furthermore, you can sometimes see cytoplasmic expression for E-cadherin, which is not normal. It can be diffuse or sometimes in a perinuclear dot-like Golgi pattern,” he said.

Dr. Schnitt showed an image of a lesion that he told the audience members they were “going to have to take on faith” is pleomorphic LCIS with aberrant E-cadherin expression and not DCIS until he proved it to them a short while later (Fig. 11). It is composed of relatively large cells and a fair amount of nuclear pleomorphism. “There are cells, though, that have intracytoplasmic vacuoles. But you can see fairly good cell membranes and kind of a mosaic pattern,” he said. The E-cadherin stain shows fairly strong membrane staining, “but again, there is some cytoplasmic staining and maybe even some perinuclear dot-like staining, which again is abnormal.” (Fig. 12).

If the pathologist is concerned that the E-cadherin staining is aberrant, Dr. Schnitt says, then doing p120 and beta-catenin stains may help clarify the nature of the E-cadherin staining because E-cadherin, p120 catenin, and beta-catenin are all part of the membrane adhesion complex. “And even when E-cadherin is expressed aberrantly, there may be abnormal expression of beta-catenin and p120 catenin. And that often helps determine whether or not the E-cadherin staining you are seeing is real or aberrant.”
The pathologist should see membrane staining for all three of these proteins in normal epithelium, and in ductal lesions, including both DCIS and invasive ductal carcinoma. In LCIS and invasive lobular carcinomas, “there is typically an absence of membrane expression for E-cadherin and beta-catenin, and cytoplasmic rather than membrane staining for p120 catenin,” he said. (Table 2).
Dr. Schnitt showed a slide with images of how the three stains would appear in an ideal world. (Fig. 13). He described a “beautiful” example of classical LCIS, the E-cadherin staining showing loss of membrane staining in the neoplastic cells. “You can see some staining of the surrounding myoepithelial cells, cytoplasmic staining for p120 catenin, and loss of membrane staining for beta-catenin.

“So in the ideal world, every lobular lesion should look like this, but as we know . . . we live in the real world,” he said. As an example of the latter, he shared an image of florid LCIS (Fig. 14). “The term florid LCIS is used when the spaces involved by LCIS show marked distension,” he says, noting that some cases have comedo necrosis and others do not. Dr. Schnitt described the lesion he was showing as having “a lot of ductal and lobular distension, but still the cells look like LCIS and they are dyshesive.”
He then showed an image of the E-cadherin stain, saying again that “on e way to interpret it is that it’s positive; therefore, it’s DCIS and not LCIS.” But he pointed out a lot of cytoplasmic staining that “makes you think it may be aberrant.” So they did additional stains, he said, which showed “beautiful cytoplasmic staining for p120, confirming a lobular phenotype and indicating that the E-cadherin expression wasaberrant. So this is, in fact, an example of LCIS.” (Figs. 15 and 16).
Dr. Schnitt also presented the pleomorphic LCIS case that he promised earlier to prove was pleomorphic LCIS rather than DCIS. “Beta-catenin membrane staining is completely absent,” he pointed out, signifying aberrant E-cadherin expression (Fig. 17).
Next, he revealed the diagnosis in the case of the 47-year-old woman who had a relatively small, solid in situ carcinoma, with a differential diagnosis of DCIS versus LCIS. The E-cadherin stain was positive but appeared “a little funny,” Dr. Schnitt recounted, so they used p120 catenin and beta-catenin. “And even before that, when you look at the normal ductal epithelium on the E-cadherin staining, it’s definitely darker and crisper in terms of membrane staining than in the lesion, which makes you think even more that this may be aberrant E-cadherin expression.”

The p120 shows “beautiful cytoplasmic staining. The beta-catenin was completely negative, so therefore this confirms that the E-cadherin staining in this case was aberrant,” and this is LCIS with necrosis (Figs. 18 and 19).
Some cases continue to be dubious after the stains are done, Dr. Schnitt says. In those situations, sometimes pathologists render a diagnosis of in situ carcinoma with ductal and lobular features, or just in situ carcinoma, and note that they are unsure if it’s ductal or lobular or say it has some ductal and some lobular features.

Dr. Shin tells cap today that studies have shown that pleomorphic LCIS and florid LCIS have notably more genetic aberrations than the classic type of LCIS. Dr. Schnitt and colleagues wrote in a 2009 article: “The histologic features, biomarker profile, and genomic instability observed in PLCIS suggest a more aggressive phenotype than CLCIS. However, clinical follow-up studies will be required to define the natural history and most appropriate management of these lesions” (Chen YY, et al. Am J Surg Pathol. 2009;33:1683–1694).
In her CAP17 talk, Dr. Shin, who didn’t participate in the research published in 2009, noted that the study authors looked at classical LCIS, pleomorphic LCIS, “which essentially looks like high-grade DCIS,” and then a subset of pleomorphic that exhibits apocrine features. She showed examples of each of the three types of lesions (Fig. 20). By using advanced techniques, including comparative genomic hybridization, the researchers were able to prove that these were all very related lesions, she said, but the apocrine subtype of pleomorphic LCIS demonstrated additional alterations indicative of greater genetic instability. The study involved 31 cases of PLCIS, including 18 non-apocrine and 13 apocrine subtypes, and 24 CLCIS cases.

Several years later, Dr. Shin joined some of those researchers, including Dr. Schnitt, in a study that included florid LCIS. The authors wrote, “The genetic characteristics of florid lobular carcinoma in situ were compared with 20 classic lobular carcinomas in situ and 21 pleomorphic lobular carcinomas in situ (which included 8 apocrine variants), from our previously published data performed on a similar array-based comparative genomic hybridization platform.” They concluded that florid LCIS “demonstrates more genomic alterations than classical lobular carcinoma in situ and shares the same genetic complexity as apocrine pleomorphic lobular carcinoma in situ” (Shin SJ, et al. Hum Pathol. 2013;44[10]:1998–2009).
“You tend to see high nuclear grade and apocrine features in pleomorphic LCIS,” Dr. Shin said, “whereas florid LCIS looks a lot like pleomorphic LCIS in the way it distributes itself. It looks like DCIS by growth pattern including massive acinar expansion, but the nuclear grade is characteristically low or low to intermediate in degree.”
In the study reported in 2013 in Human Pathology, however, the number of chromosomes with breakpoints was higher in florid LCIS than pleomorphic LCIS, which Dr. Shin told the CAP17 audience “seems counterintuitive” because she had told them that the nuclear grade was lower in florid LCIS than in pleomorphic LCIS. “So still a little bit of a mystery there,” she said.
Dr. Shin reviewed the clinicopathologic features of classical LCIS and LCIS variants. For classical LCIS, the mean age in the study group was about 50, but for florid LCIS and pleomorphic LCIS, particularly the apocrine subtype, the patients were older and in the postmenopausal age group of 55 to 60.
As for clinical management, Dr. Schnitt says there is concern that the LCIS variants may, in fact, be more biologically similar to DCIS than to classical LCIS and should perhaps be treated more like DCIS. Yet “there are really no good outcome data to support that view. So in the absence of data, is it better to overtreat or undertreat? Clinicians fall on both sides of that. But there really is no consensus about this.”
Tari King, MD, chief of breast surgery at Dana-Farber/Brigham and Women’s Cancer Center, tells cap today that the only direct evidence that LCIS variants are worse or potentially more aggressive than classical LCIS is that when a variant is diagnosed, there is frequently already a cancer present. Therefore, she and colleagues recommend patients diagnosed with an LCIS variant on a core biopsy undergo surgical excision to rule out an associated carcinoma. “When you take these women to the operating room for the initial surgical biopsy, you will actually find breast cancer in anywhere from 20 to 60 percent of cases, depending on which series you want to quote in the literature,” says Dr. King, who is also associate division chief for breast surgery at Brigham and Women’s Hospital and associate chair for multidisciplinary oncology.
Dr. King says they recommend trying to achieve clear margins for LCIS variants. She adds, however, that they have “no data to suggest that achieving clear margins results in a lower risk of breast cancer or a lower risk of having a future event. This is essentially a pragmatic approach.” She also recommends the pathologist perform staining for the estrogen receptor on the LCIS variants. Many of them will be ER positive, she says, “and we do have medications that are very efficacious at decreasing the risk of developing an ER-positive breast cancer.”
On the other hand, Dr. King says they don’t routinely recommend radiation therapy for LCIS variants. “There are some radiation oncologists who lean toward radiating, which means they lean toward treating them like DCIS. I lean away from that, given the lack of data on the natural history of these lesions and the known risks associated with radiation,” she says.
Dr. King points to what she calls a major controversy in the DCIS field where “we are trying to identify which women with DCIS don’t actually need all the treatment that we are recommending. So I think it behooves us to try to take a less is more approach for these other lesions that we don’t quite understand and capture their natural history to see when and or if these women will ever develop breast cancer, because that’s the concern.” In the entire literature, she notes, there is information about the natural history of LCIS variants in fewer than 100 cases.
Dr. Shin says that much of what has been gleaned about pleomorphic LCIS is anecdotal, “because we find out later that the patient didn’t do well [e.g. metastatic pleomorphic lobular carcinoma], and when we re-review their pathology, we realize it was pleomorphic LCIS, but maybe at the time it was mistaken for DCIS because they do look similar.” Even if the lesion is recognized up front, the current treatment varies considerably, and that too makes it difficult five or 10 years later to return to these cases and learn from them.
Will there ever be enough data for a more evidence-based approach? Dr. King thinks a couple of things would have to occur for that to become reality. One has to do with “our pathologists, whom I have the utmost respect for, so this is not meant in a negative way at all,” she says, “but the pathology community really needs to come together and define a nomenclature so that we all know we are talking about the same lesions. There are a lot of different terms being used to describe these LCIS variants, and if something truly meets the criteria of pleomorphic LCIS, then everybody needs to call it pleomorphic LCIS.” The same for florid LCIS and LCIS with necrosis. “I don’t think we will ever get anywhere until we have established a consistent nomenclature and people use it so that we can collect information and follow the natural history,” Dr. King says.
There also needs to be agreement on treatment, such as “radiating or not radiating,” she adds. “We need to agree upon nomenclature and we need to agree upon practice, so that we can then document outcomes and figure out how aggressive or not these lesions actually are.”
Dr. Shin said she thinks “the heterogeneity of LCIS, like DCIS, is real and that this heterogeneous group really encompasses lesions that differ in morphologic features, immunophenotype, genetic alterations, and clinical behavior.”
Dr. Shin also noted that the eighth edition of the American Joint Committee on Cancer staging manual “has taken away LCIS entirely.” She is hoping that for the ninth edition, “maybe we can get LCIS back in there potentially, just to focus on the LCIS variant, which obviously may be a worse actor than the classical type.”
[hr]
Karen Lusky is a writer in Brentwood, Tenn. Images in Figs. 1–19 are courtesy of Dr. Stuart Schnitt.
CAP18 will take place Oct. 21–24 in Chicago.